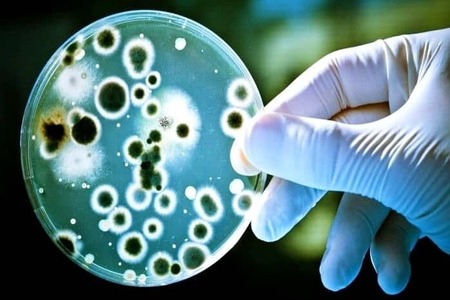

Samsara Eco to develop plastic-eating enzyme for recycling
YarnsandFibers News Bureau 2024-07-01 12:43:43 – AustraliaAustralian recycling company Samsara Eco has secured $65 million to advance its plastic-eating enzyme technology, which aims to recycle materials that would otherwise end up in landfills.
The funds will be used to establish commercial facilities in Southeast Asia, including a nylon factory and a polyester facility. These sites will have the capacity to recycle “millions of tonnes” of plastic waste from nearby garment factories, significantly reducing environmental impact.
Samsara Eco utilizes AI to create plastic-eating enzymes capable of breaking down commonly-used plastics into their original building blocks, enabling what the company calls “infinite recycling.” This technology offers a key advantage as it does not require plastics to be sorted before recycling, simplifying the process.
The commercial facilities will be 50:50 joint ventures between Samsara Eco and plastic polymerization companies. The partnership aims to expedite the market introduction of this innovative technology.
Samsara Eco’s CEO Riley commented: “Our partners are drawing us to market quickly. It really is an exciting inflection point in the business to have the capital platform to go faster to commercialize and work with our partners to bring the technology to market.”
Market Intelligence
Ask for free sample Report

experience
Customer Base
dedicated team
Countries Served Worldwide









